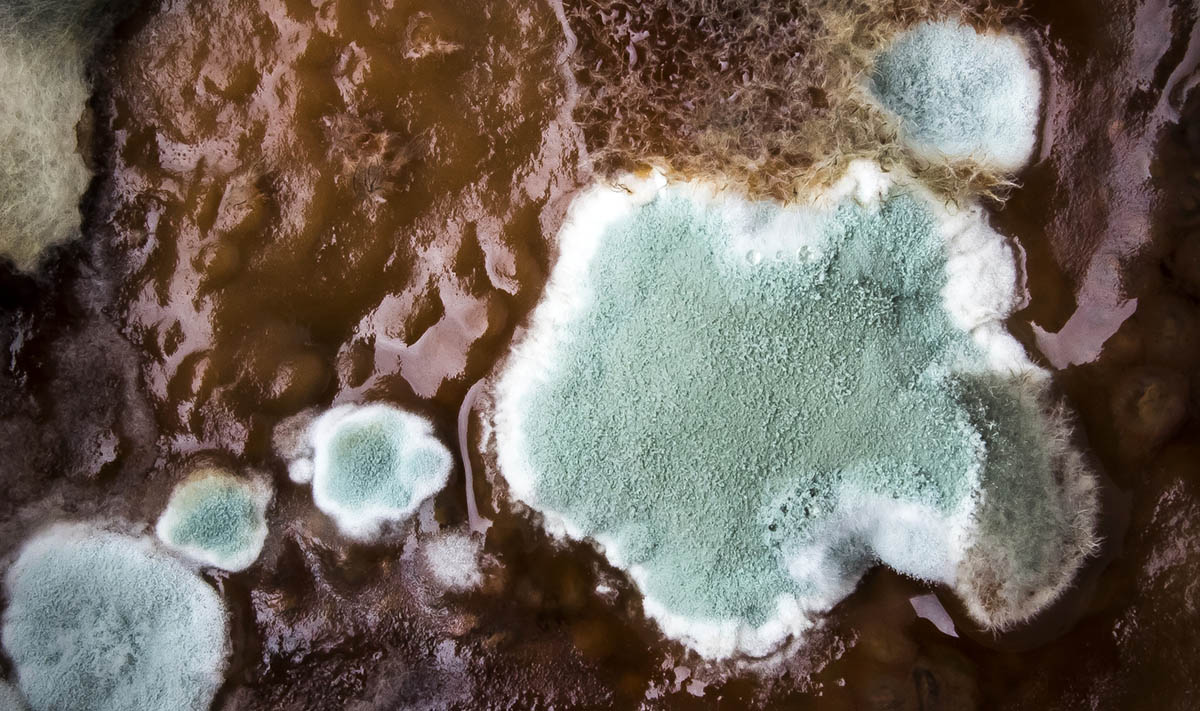

«В меру познавательное, но бессмысленное док-кино про старую добрую плесень»



ОРТ-шная документалка, вызвавшая некий резонанс в рунете, которую по настоянию жены, т.к. она ее не смогла ухватить по ТВ, мы скачали и посмотрели. Слабенькая по качеству, явно наигранная и фальшивая, но при этом обладающая некими вполне любопытными фактами и визуальными приемами документальная безделушка о роли плесневых грибов в истории получалилась. Шока и каких-то откровений для образованного зрителя тут не будет. Не лучшее документальное кинцо. Но 95 минут на просмотр не очень жалко...


Плесень ~ Черный ястреб 214356